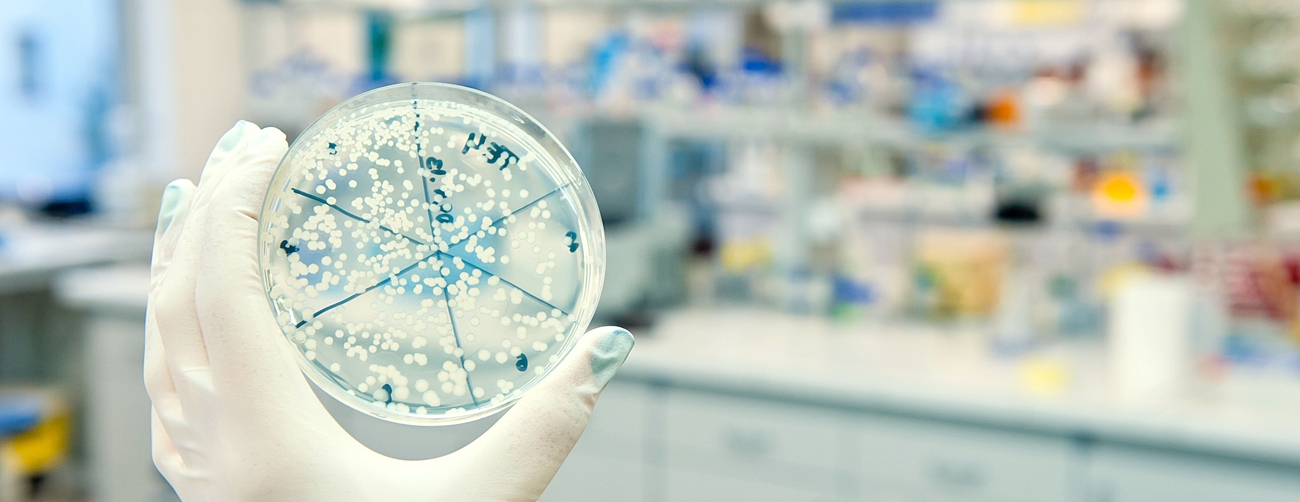

Antagningspoäng
20.57
Lägsta poäng 2025
1.6
Lägsta poäng 2025
20.78
Lägsta poäng 2025
* (Alla antagna)
Lägsta poäng 2025
4
Lägsta poäng 2025
Chalmers tekniska högskola
5 år
20.57
Lägsta poäng 2025
1.6
Lägsta poäng 2025
20.78
Lägsta poäng 2025
* (Alla antagna)
Lägsta poäng 2025
4
Lägsta poäng 2025
85 studenter per år
71 % kvinnor
29 % män
Inom biotekniken kombineras studier av levande organismer och deras biologiska och kemiska processer för att utveckla livsförbättrande produkter för människor, djur och natur. Det kan vara att skapa banbrytande mediciner, utveckla förnybara bränslen, producera framtidens mat eller att göra bioteknikindustrin mer hållbar.
Chalmers bioteknikprogram har utvecklats för att möta framtidens behov och ger dig kunskaper i cellbiologi och kemi, matematik och programmering, samt human anatomi och fysiologi. Här lär du dig hur celler och avancerade organismer fungerar och hur man kan manipulera dessa för att skapa lösningar och produkter som gör skillnad. Det kan innebära att utveckla nya effektiva läkemedel eller biologiska reservdelar så som organ, specifika celler och protein, optimera biologiska processer för produktion av exempelvis enzymer, livsmedel och energi, eller utveckla avgiftningsstrategier för organismer i förorenade miljöer. Möjligheterna är oändliga, och just dina idéer kan forma framtiden.
Som civilingenjör med inriktning bioteknik kan du jobba med forskning och utveckling på universitet (naturvetenskapliga, tekniska, medicinska eller farmaceutiska fakulteter), inom biomedicinsk laboratorieverksamhet, inom industrier som tillverkar och utvecklar till exempel läkemedel, livsmedel, biomaterial och biokemiska och kemiska produkter.
Områden studenterna kommer från
Natur
84 %
Teknik
10 %
Estet
2 %
Fysik 2
Kemi 1
Engelska 6
Matematik 4
Börjar på hösten
Ansök senast 15 april
300 högskolepoäng
Civilingenjörsexamen och Kandidatexamen
Heltidsstudier (100%)
Anmälningskod på Antagning.se: CTH-48000



Chalmers tekniska högskola, eller bara Chalmers, grundades 1829. Universitetet är känt för sina ingenjörsutbildningar, men erbjuder bland annat även utbildningar inom arkitektur och sjöfart. Universitetets motto är “Avancez”, vilket betyder “framåt”. Chalmers har två huvudsakliga campus i Göteborg: Johanneberg och Lindholmen. På Johanneberg finns fokus på de traditionella ingenjörsutbildningarna, medan Lindholmen är inriktat på IT samt sjöfart. Verksamheten på Lindholmen ska snart minska för grundutbildningsstudenter men inte försvinna helt. Chalmers grundades av William Chalmers, en svensk handelsman, då under namnet Chalmersska slöjdskolan och fick universitetsstatus 1937. Universitetet är ägt av en stiftelse men får betydande statligt stöd.
Antal studenter
9 692
Grundat
1829